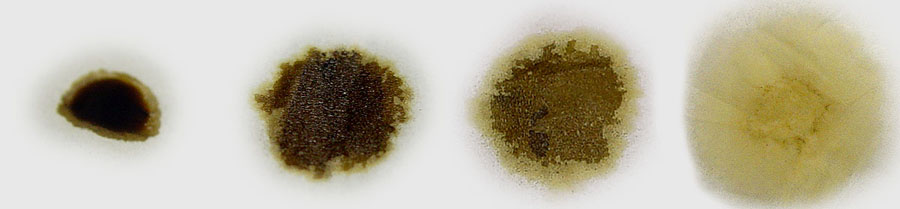

今年も残すところ僅かになりました。弊社製品ご愛用を頂いている皆様方には大変お世話になりましたことをこの場を借りまして深く感謝申し上げます。すべてはお客様のご満足が得られますよう社員一同心掛けておりますが充分に行き届かなかった部分も幾つかあるかと思われます。来社のおりでも、ご意見ご希望を伝えてくださいますれば前向きに検討させていただきます。ご来社されたお客様との、なにげない会話の中で「!」と急にアイデアやヒントを得る場合が多々あります。実際に使用され体験された中での体験談の中に自分では感じなかった新たな発見をさせていただく場合もあります。世の中には上には上があるものだと思い知らされる出来事がありました。つい最近の注文の電話の中で、「新車からオートマにX1、エンジンにエストレモオイルを使用してきて現在、48万kmになった」と言うのです。「車種は?」「日産プレサージュ」「ATはオーバーホールしたのですか?」「新車からオートマもエンジンも一度もOHしていません」「ATFは何万km毎に交換しているのですか?」「新車からX1を添加して5万km毎に交換しています」「凄いですね」と逆に私の方が驚かされました。現在の調子も燃費もすこぶる良いそうで、年間走行距離が5万kmと多いという話なので、この方にとってなくてはならない製品に違いありません。ネットで検索すると、X1を一度も使用されない方の中には「オートマは複雑な構造なので添加剤など入れたら怖い」とか疑心暗鬼になられる方も見受けます。どんな物でも実際に体験していないと怖さが先に立つものです。私は実績しか検証していませんので、エストレモを使用していない車は逆に怖いです。エストレモを使って初めて安心して車を運転できます。まだまだ、新しい発見をしていますので出来る限り製品に反映させ、皆様方の期待に答えて行きたいと願って年末の挨拶と致します。1年間ありがとうございました。
皆々様にとって良き新年となりますよう祈念致します。
45年前のトヨペット・クラウン、弊社製品使用レポートと写真が送付されましたので、掲載させて頂きます。
前略
5月21日に貴社H/P「藤沢名人の部屋」に載せて頂いた者です。この度、5月のリポート後の報告。特に顕著な効果が出た貴社オリジナルオイルについての報告させていただきたく、又、私の愛車の写真も合わせて載せていただければ、なお嬉しいなと思い送付させていただきました。愛車は昭和38年式 トヨペットクラウン・デラックス(以後、型式のRS41とする)です。これまでは、旧車用オイルを使わねばと思い、○○○○○○(20W-50)を使用。それにX1を15%添加しました。それでも顕著な効果があって高速でも110km/h位は出ました。2004年頃、試しにとHDX1の極を使用。するとどうでしょう、以前のオイル使用時より早く効果を実感。それだけでなく、アクセルを軽く踏むと100km/hに、すぐに達しました。まるで異次元の世界です。じゃあ何故、04年以降、HDX1を使わなかったというと、夏場に10W-40では、オイルダレをしてスタミナ不足になるのでは?と心配した為です。そもそも、この時代の車は、ピストンクリアランスが広いので固い鉱物油が求められます。但し当地、秋冬は固いオイルではクランクに抵抗が掛かるので10W-40で丁度です。しかし、今年に入り、○○○○○○・○○○○○の入手が難しくなり、又、廃油処理車(一度使用したオイルを再利用)平成4年式クラウンが廃車になり、この際、オールシーズンHDX1でやろうと考えました。更に今年は予想もしなかった酷暑、広報に「過酷になればなるほど強さを発揮」を信じ利用しました。結果、オイル喰いはあったもの(補充をしたが)心配してたオイルダレはなく楽々乗りきりました。更に、私の車、純正トランククーラー付きで、コンプレッサーは世界最大級、エンジンにとって更に過酷ですが、それにも、めげる事はありませんでした。
それだけでレポートは終わりません。東京、千葉、新潟と、かなり遠距離を走り、毎回高速走行したが、驚いたことに000km/h+20km巡行が楽でした。エンジン回転は滑らかそのもので、抵抗が感じず、音も静か、お陰で車内ではラジオ(AMのみ)がストレスなく聞け、大好きな大相撲も楽しめました。今も相変わらず、エンジン本体はノンOHで、一定区間で120km/h走行はやめてます。それでも、合流での加速で一気に90km/hまで加速、又、追い越しも000km+30km/h位で難なくできます。これが45年も前の車だとダレも信じないでしょう。
他の製品では、これまで、ガソリン添加剤V7FS,G9FSは余り効果の実感がなかったものの、HDX1をメインにしたら、やはり黒煙が減少し、燃費も良くなりました。かなり相性がいいです。LLC添加剤は、今年の様な夏には大活躍です。クーラー使用もかなり長かったが水温上昇さほどでもなく、ほぼ一定でした。改めて凄いと思った所です。2002年より愛用させて頂き、丸5年以上になりました。RS41の全身はX1漬けで、年々調子が良くなって居る事は、かなり強く実感します。又、この1年で、どの位走ったか調べてみたら、な、なんと8000キロでした。40年を軽くオーバーした車だが全くトラブルなく、日本の平均的オーナードライバーの1年間の走行の1.5倍も走っており、皆にたまげられてます。(足車のグロリアバンは年間4000キロだった)
使用開始は95226kmからで、12月22日現在の走行距離は124706kmです。使用を始めてから29480km走行。